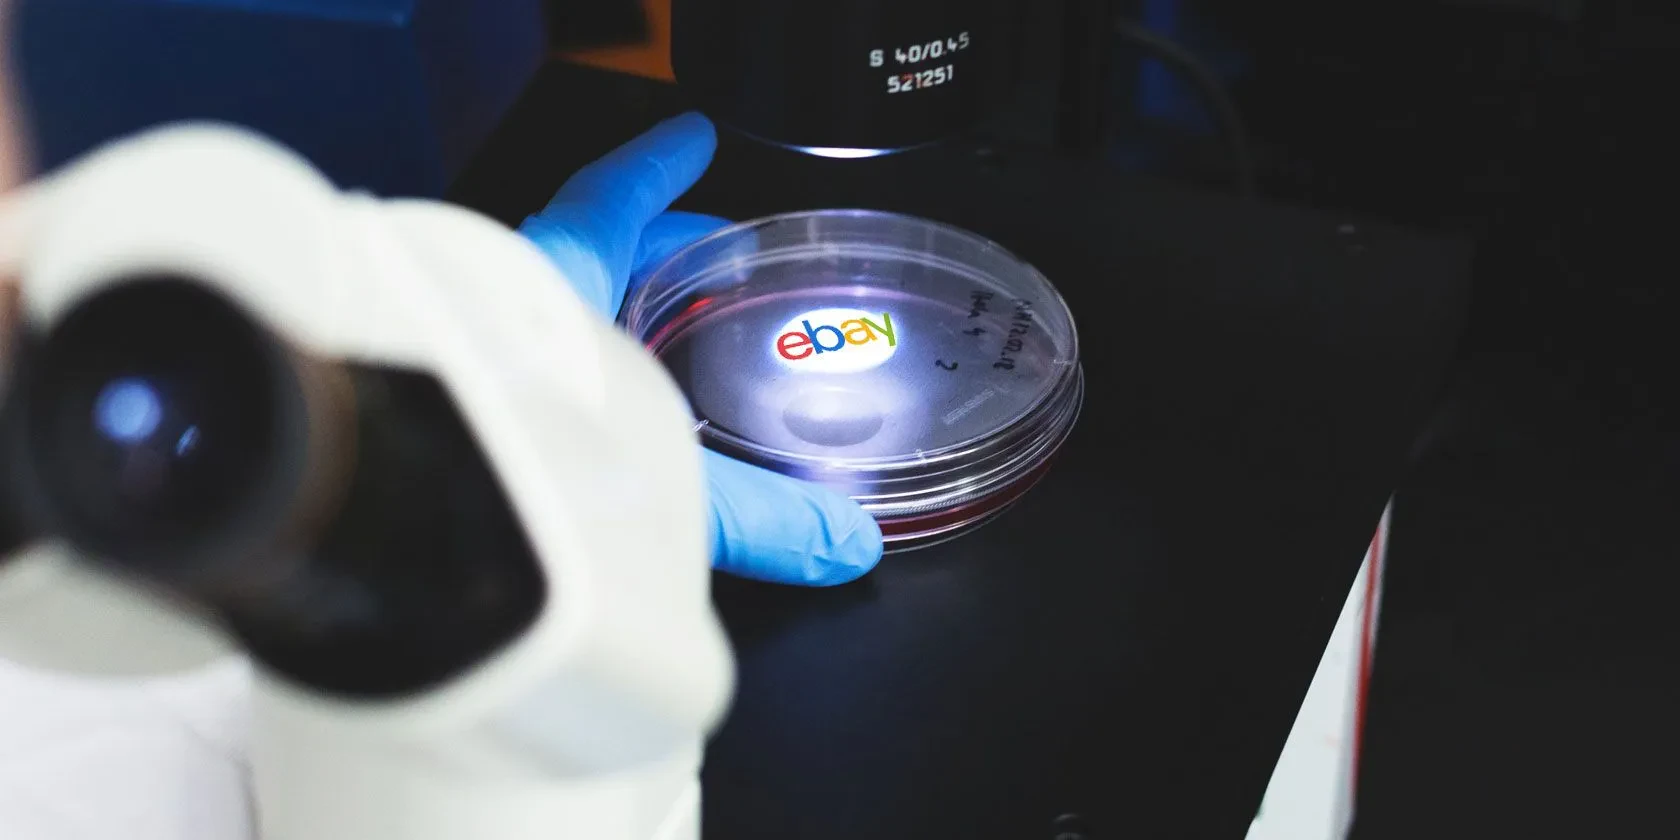

So, you’ve got a fantastic diecast model car, maybe a classic muscle car, a sleek sports car, or a vintage truck. You love it, you cherish it, and then… disaster strikes. A tiny part breaks off – a mirror, a wheel, a headlight. Suddenly, your perfect model is less than perfect. But don’t worry, you’re not alone, and there are ways to fix it!
Finding replacement parts, or spares, for diecast models can seem like a daunting task. These little cars are often incredibly detailed, and the parts are, well, tiny. But with a little patience and know-how, you can often find exactly what you need to restore your beloved model to its former glory.
Where to Find Diecast Spares
The hunt for diecast spares can be an adventure in itself. There are several places you can try, each with its own pros and cons.
Online Marketplaces
Sites like eBay and Amazon are treasure troves of diecast parts. You can often find individual parts, sets of parts, or even entire donor cars to cannibalize for spares. Remember to use very specific search terms – the make, model, year (2024), and the specific part you need. For example, instead of ‘diecast parts’, try ‘1967 Ford Mustang diecast headlight’.
Specialized Diecast Websites and Forums
Many websites and online forums are dedicated to diecast collecting. These communities often have members who specialize in sourcing or selling parts. It’s a great place to connect with other collectors who might have the part you need, or know where to find it.

Local Hobby Shops
Your local hobby shop might have a small selection of diecast spares, or know someone who does. It’s always worth checking!
Model Show and Swap Meets
Attending model shows and swap meets can be a great way to find rare or hard-to-find parts. You can network with other collectors and find hidden gems.

Tips for Finding the Right Parts
- Be as specific as possible when searching online.
- Check the manufacturer’s website – sometimes they sell replacement parts.
- Take clear photos of the broken part for reference.
- Don’t be afraid to ask for help in online forums or communities.
- Be patient – finding the right part can take time.
Finding diecast spares takes dedication, but the satisfaction of restoring your beloved model is well worth the effort. Happy hunting!
Remember to always handle your diecast models with care to avoid further damage! A little prevention goes a long way.
And who knows, your search for spares might even lead you to discover new models and expand your collection! The world of diecast collecting is vast and full of surprises.